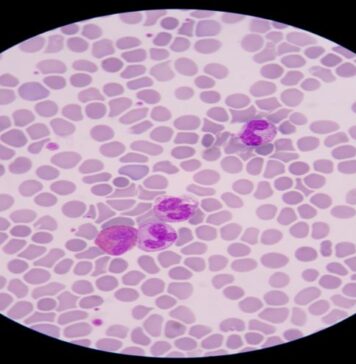
బ్లడ్ పాయిజనింగ్ ప్రాణాంతకమా.? లక్షణాలు, చికిత్స.! Blood Poisoning_ Key Symptoms and How to Treat It

అక్రోమెగలీ: కారణాలు, లక్షణాలు మరియు చికిత్స - Acromegaly: Causes, Symptoms and Treatment...
అక్రోమెగలీ అనేది పెద్దలలో వచ్చే ఒక అరుదైన హార్మోన్ల సంబంధిత పరిస్థితి. దీనివల్ల కొన్ని ఎముకలు, అవయవాలు మరియు ఇతర కణజాలాలు పెద్దవిగా పెరుగుతాయి. మెదడులోని పిట్యూటరీ గ్రంథి అనే చిన్న గ్రంథి,...
ఊపిరితిత్తుల క్యాన్సర్: పురోగతి, మరియు చికిత్స - Lung Cancer: progression, doubling time...
ఊపిరితిత్తుల క్యాన్సర్ ఎంత వేగంగా పెరుగుతుంది? వ్యాప్తి చెందడానికి ఎంత సమయం పడుతుంది? అన్నది తెలిస్తే చాలా మంది ఆశ్చర్యపోతారు. ఊపిరితిత్తుల క్యాన్సర్ ఎంత సమయంలో రెట్టింపు స్థాయికి చేరుతుంది? లేదా అది...
స్ప్లెనోమెగలీ (ప్లీహము)- లక్షణాలు, కారణాలు, చికిత్స
స్ప్లెనోమెగలీ అంటే శరీరంలోని ప్లీహము విస్తరించడం వల్ల ఏర్పడే పరిస్థితి. దీనిని సాధారణంగా విస్తారిత ప్లీహము లేదా ప్లీహము విస్తరణ అని కూడా అంటారు. ప్లీహము శోషరస వ్యవస్థలో ఒక భాగం. ఇది...
తరచుగా ఒళ్లు నోప్పులా.. కారణాలు తెలుసా? మాత్రలే మార్గమా?
ఐశ్వర్యం కన్నా ఆరోగ్యమే మిన్న. ఎంతటి సంపద ఉన్నా అరోగ్యంగా లేరంటే అనుభవించలేరు. అయితే ఆరోగ్యంగా ఉన్నారంటే ఐశ్వర్యాన్ని సంపాదించినట్టే. అయితే అనారోగ్యం సమస్యలను చికిత్సలతో, వైద్యులు రాసి ఇచ్చే మాత్రలతో అడ్డుకట్ట...
హెర్పాంగినా: కారకాలు, లక్షణాలు, చికిత్స మరియు నివారణ - Herpangina: Symptoms, Causes, Treatment...
హెర్పాంగినా అనేది ఒక వైరల్ వ్యాధి, ఇది ఎక్కువగా చిన్నారులలో కనిపిస్తుంది. దీని వలన వారిలో తీవ్రమైన జ్వరం, నోరు మరియు గొంతులో బొబ్బలు లాంటి పుండ్లు వస్తాయి. ఇది అంటువ్యాధి. ఒకరి...
బ్లాడర్ పేస్మేకర్స్: ప్రయోజనాలు, సంభావ్య దుష్ప్రభావాలు - Bladder Pacemakers: Benefits and Potential...
న్యూరోజెనిక్ మూత్రాశయం అనేది మూత్ర నాళ సమస్యలకు ఒక రకం చికిత్స. నరాలు దెబ్బతినడం వల్ల మూత్రాశయంలో మూత్రాన్ని నిలుపుకోలేక ఏర్పడే పరిస్థితి. ఈ పరిస్థితికి చికిత్స చేసే విధానంలో సక్రాల్ న్యూరోమోడ్యులేషన్ను...
పంటి చీము గడ్డ: కారకాలు, లక్షణాలు మరియు చికిత్స - Tooth Abscess: Causes,...
దంతపు చిగుళ్లలో గడ్డ ఏర్పడింది అంటే అది చీముతో కూడిన పాకెట్ (ఇన్ఫెక్షన్). ఇది నోటి కణజాలాలను దెబ్బతీస్తుంది. అంతేకాదు మీ నోటిలోని ఇతర ప్రాంతాలకు కూడా వ్యాపిస్తుంది, కొన్ని సందర్భాల్లో తీవ్రమైన...
మలబద్దకాన్ని నియంత్రించే 12 ఆహారాలు గురించి మీకు తెలుసా?
మలబద్దకం సమస్య అన్నది ఎంత ఇబ్బందికరమో అనుభవించేవారికే తెలుస్తుంది. ఏదిబడితే అది ఎప్పుడుపడితే అప్పుడు తింటూ.. మరీముఖ్యంగా ఫాస్ట్ ఫుడ్స్, మసాలా నిండిన ఆహారాలను అరగిస్తూ.. మలబద్దకానికి గురవుతున్నారు. ఈ క్రమంలో దీర్ఘకాలిక...
హెపటైటిస్ అంటే ఏమిటి? రకాలు, లక్షణాలు, కారణాలు - Hepatitis: Types, symptoms, and...
కాలేయం వాపుకు గురైతే దానిని హెపటైటిస్ అని అంటారు. మద్యపాన సేవనంతో పాటు కలుషిత ఆహారం, కలుషిత నీరు తీసుకోవడం ద్వారా అనేక ఆరోగ్య పరిస్థితులు, కొన్ని మందులు ఈ పరిస్థితికి కారణం...
వికారం గురించి తెలుసుకోవాల్సిన అన్ని విషయాలు ఇవే.! - Nausea: Understanding the Causes,...
వికారం అనేది కడుపులో అసౌకర్యం కలిగి ఉండటం మరియు వాంతి చేయాలన్న భావనతో కూడి ఉంటుంది. కడుపులో అసౌకర్యం కలిగిస్తున్న పదార్ధాలను వాంతి ద్వారా బయటకు పంపి వేయాలన్న భావనను కలిగిస్తుంది. ఇలా...